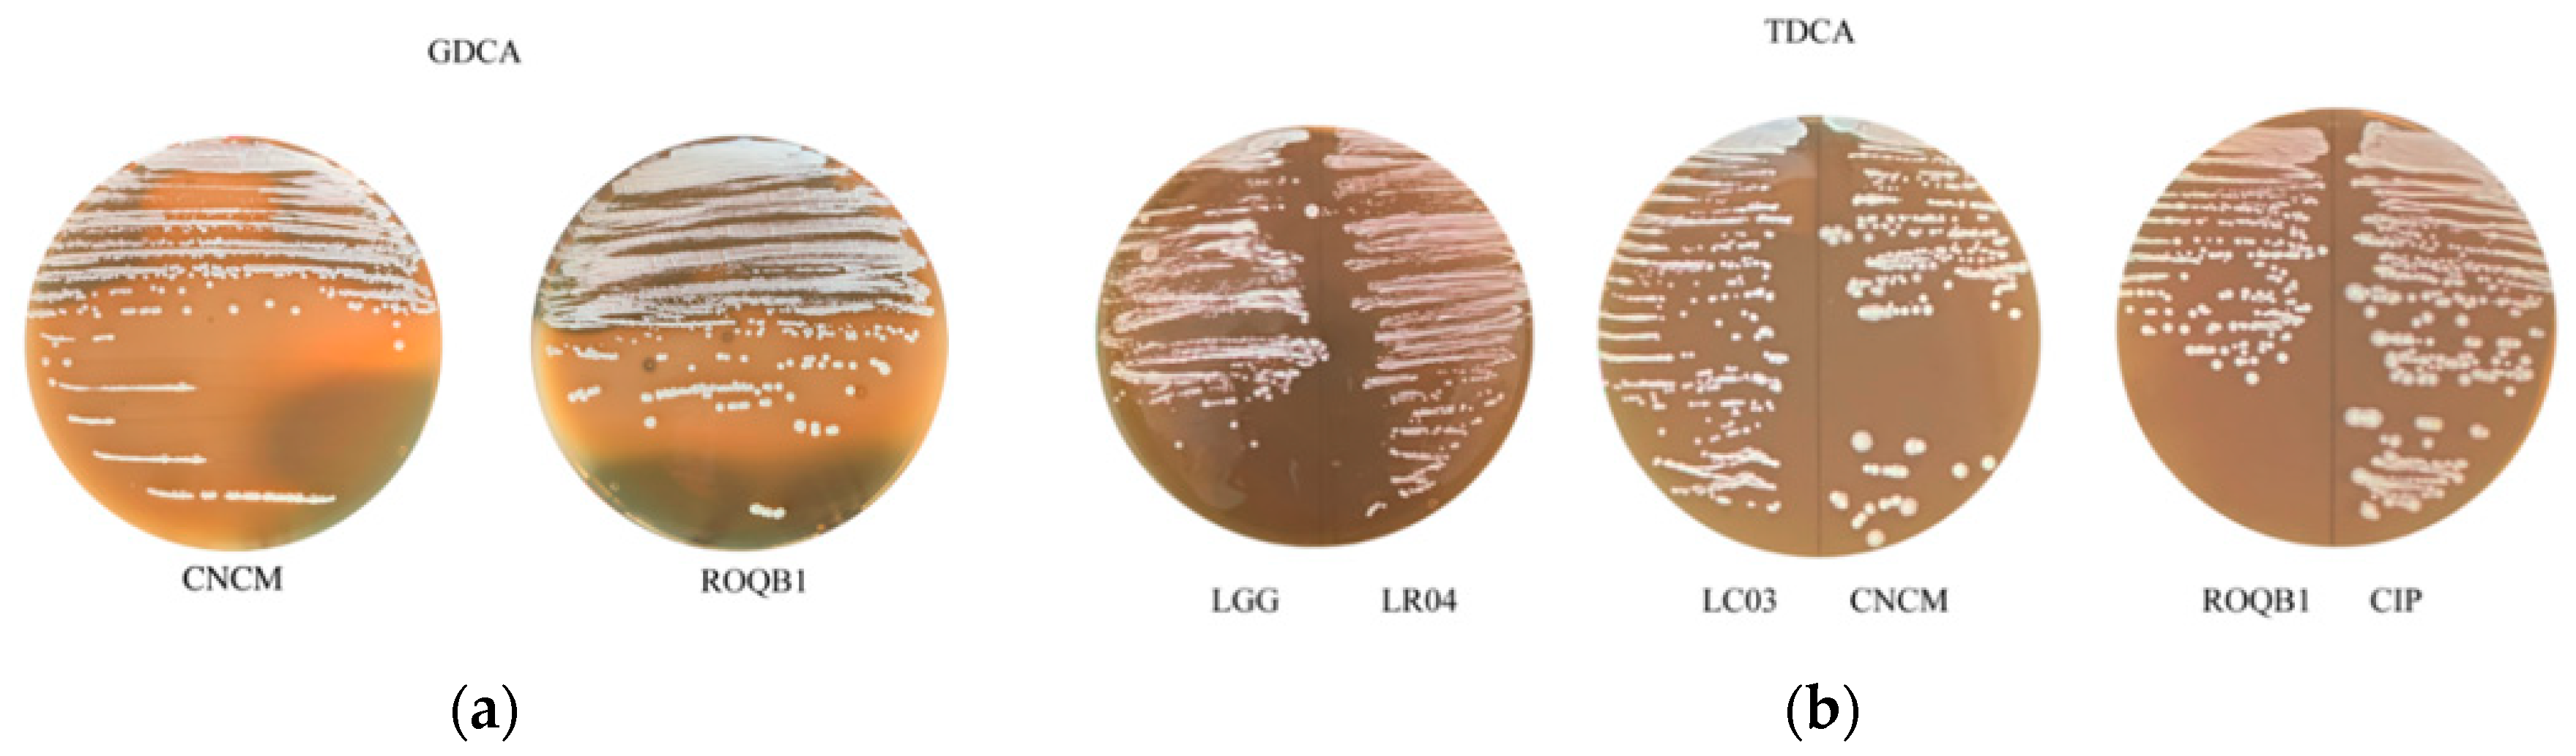
Microorganisms 08 01053 g005 Microorganisms 08 01053 g005

Evaluation of the Probiotic Properties and the Capacity to Form Biofilms of Various Lactobacillus Strains
Abstract
1. Introduction
2. Materials and Methods
2.1. Bacterial Strains and Growth Conditions
2.2. Cell Cultures
2.3. Study of Intestinal Permeability by the Measurement of Transepithelial Electrical Resistance (TEER)
2.4. Capacity of the Strains to Adhere to Intestinal Epithelial Cells
2.5. Biofilm Structural Dynamics
2.6. Comparison of Resistance to Stressful Conditions Depending on the Mode of Growth of the Lactobacillus Strains
2.6.1. Planktonic Form
2.6.2. Biofilm Form
2.7. Bile Salt Hydrolase Assays
2.8. Analysis of Gamma-Aminobutyric Acid (GABA) in Culture Supernatants
2.9. Statistics
3. Results
3.1. Modulation of Intestinal Permeability in Cellular Models
3.2. Capacity of the Strains to Adhere to Intestinal Epithelial Cells
3.3. Analysis of Biofilm Formation by the Selected Lactobacilli Using Confocal Laser Scanning Microscopy (CLSM)
3.4. Comparison of Tolerance to Stressful Conditions Depending on Lifestyle
3.5. Bile Salt Hydrolase Assays
3.6. Secretion of the Neurotransmitter γ-Aminobutyric Acid (GABA)
4. Discussion
5. Conclusions
Supplementary Materials
Author Contributions
Funding
Conflicts of Interest
References
- Hill, C.; Guarner, F.; Reid, G.; Gibson, G.R.; Merenstein, D.J.; Pot, B.; Morelli, L.; Canani, R.B.; Flint, A.J.; Salminen, S.; et al. The International Scientific Association for Probiotics and Prebiotics consensus statement on the scope and appropriate use of the term probiotic. Nat. Rev. Gastroenterol. Hepatol. 2014, 11, 506–514. [Google Scholar] [CrossRef] [PubMed]
- Bermudez-Brito, M.; Plaza-Díaz, J.; Muñoz-Quezada, S.; Gómez-Llorente, C.; Gil, A. Probiotic Mechanisms of Action. Ann. Nutr. Metab. 2012, 61, 160–174. [Google Scholar] [CrossRef]
- Donlan, R.M.; Costerton, J.W. Biofilms: Survival Mechanisms of Clinically Relevant Microorganisms. Clin. Microbiol. Rev. 2002, 15, 167–193. [Google Scholar] [CrossRef]
- Flemming, H.-C.; Wingender, J.; Szewzyk, U.; Steinberg, P.; Rice, S.A.; Kjelleberg, S. Biofilms: An emergent form of bacterial life. Nat. Rev. Microbiol. 2016, 14, 563–575. [Google Scholar] [CrossRef] [PubMed]
- Olson, J.K.; Navarro, J.B.; Allen, J.M.; McCulloh, C.J.; Mashburn-Warren, L.; Wang, Y.; Varaljay, V.A.; Bailey, M.T.; Goodman, S.D.; Besner, G.E. An Enhanced Lactobacillus Reuteri Biofilm Formulation that Increases 2 Protection Against Experimental Necrotizing Enterocolitis. Am. J. Physiol. Gastrointest. Liver Physiol. 2018, 315, G408–G419. [Google Scholar] [CrossRef]
- Rieu, A.; Aoudia, N.; Jego, G.; Chluba, J.; Yousfi, N.; Briandet, R.; Deschamps, J.; Gasquet, B.; Monedero, V.M.; Garrido, C.; et al. The biofilm mode of life boosts the anti-inflammatoryproperties of Lactobacillus. Cell Microbiol. 2014, 16, 1836–1853. [Google Scholar] [CrossRef] [PubMed]
- Gilbert, J.A.; Quinn, R.A.; Debelius, J.; Xu, Z.Z.; Morton, J.; Garg, N.; Jansson, J.K.; Dorrestein, P.C.; Knight, R. Microbiome-wide association studies link dynamic microbial consortia to disease. Nature 2016, 535, 94–103. [Google Scholar] [CrossRef] [PubMed]
- Kawano, M.; Miyoshi, M.; Ogawa, A.; Sakai, F.; Kadooka, Y. Lactobacillus gasseri SBT2055 inhibits adipose tissue inflammation and intestinal permeability in mice fed a high-fat diet. J. Nutri. Sci. 2016, 5, 1–9. [Google Scholar] [CrossRef]
- Han, X.; Lee, A.; Huang, S.; Gao, J.; Spence, J.R.; Owyang, C. Lactobacillus rhamnosus GG prevents epithelial barrier dysfunction induced by interferon-gamma and fecal supernatants from irritable bowel syndrome patients in human intestinal enteroids and colonoids. Gut Microbes 2019, 10, 59–76. [Google Scholar] [CrossRef]
- Zhao, H.; Zhao, C.; Dong, Y.; Zhang, M.; Wang, Y.; Li, F.; Li, X.; McClain, C.; Yang, S.; Feng, W. Inhibition of miR122a by Lactobacillus rhamnosus GG culture 2 supernatant increases intestinal occludin expression and protects mice 3 from alcoholic liver disease. Toxicol. Lett. 2015, 9023, 194–200. [Google Scholar] [CrossRef]
- Ait-Belgnaoui, A.A.; Han, W.; Lamine, F.; Eutamene, H.; Fioramonti, J.; Bueno, L.; Theodorou, V. Lactobacillus farciminis treatment suppresses stress induced visceral hypersensitivity: A possible action through interaction with epithelial cell cytoskeleton contraction. Gut 2006, 55, 1090–1094. [Google Scholar] [CrossRef] [PubMed]
- Camilleri, M. Leaky gut: Mechanisms, measurement and clinical implications in humans. Gut 2019, 68, 1516–1526. [Google Scholar] [CrossRef] [PubMed]
- FAO/WHO. Guidelines for the Evaluation of Probiotics in Food; Ontario: London, UK, 2002. [Google Scholar]
- De Melo Pereira, G.V.; de Oliveira Coelho, B.; Magalhães Júnior, A.I.; Thomaz-Soccol, V.; Soccol, C.R. How to select a probiotic? A review and update of methods and criteria. Biotechnol. Adv. 2018, 36, 2060–2076. [Google Scholar] [CrossRef] [PubMed]
- Bridier, A.; Dubois-Brissonnet, F.; Boubetra, A.; Thomas, V.; Briandet, R. The biofilm architecture of sixty opportunistic pathogens deciphered using a high throughput CLSM method. J. Microbiol. Methods 2010, 82, 64–70. [Google Scholar] [CrossRef] [PubMed]
- MIMA2. Microscopy and Imaging Facility for Microbes, Animals and Foods (MIMA2); INRAE: Paris, France, 2018. [Google Scholar] [CrossRef]
- National Institute of Health, ImageJ. Available online: https://imagej.nih.gov/ij/index.html (accessed on 19 March 2019).
- Moser, S.A.; Savage, D.C. Bile Salt Hydrolase Activity and Resistance to Toxicity of Conjugated Bile Salts Are Unrelated Properties in Lactobacilli. Appl. Environ. Microbiol. 2001, 67, 3476–3480. [Google Scholar] [CrossRef] [PubMed]
- Salazar, C.; Armenta, J.M.; Cortès, D.; Shulaev, V. Combination of an AccQ·Tag-Ultra Performance Liquid Chromatographic Method with Tandem Mass Spectrometry for the Analysis of Amino Acids. In AminoAcid Analysis: Methods and Protocols, Methods in Molecular Biology; Alterman, M.A., Hunziker, P., Eds.; Humana Press: Totowa, NJ, USA, 2012; pp. 13–28. [Google Scholar] [CrossRef]
- Collado-González, J.; Cruz, Z.N.; Medina, S.; Mellisho, C.; Rodríguez, P.; Galindo, A.; Egea, I.; Romojaro, F.; Ferreres, F.; Torrecillas, A.; et al. Effects of water deficit during maturation on amino acids and jujube fruit eating quality. Maced. J. Chem. Chem. Eng. 2014, 33, 1857–5552. [Google Scholar] [CrossRef]
- Riga, P.; Gil-Izquierdo, Á.; Villaño, D.; Benedicto, L.; García-Flores, L.; Medina, S. Rootstock effect on serotonin and nutritional quality of tomatoes produced under low temperature and light conditions. J. Food Compos. Anal. 2016, 46. [Google Scholar] [CrossRef]
- Riga, P.; Benedicto, L.; Gil-Izquierdo, Á.; Collado-González, J.; Ferreres, F.; Medina, S. Diffuse light affects the contents of vitamin C, phenolic compounds and free amino acids in lettuce plants. Food Chem. 2019, 272. [Google Scholar] [CrossRef]
- Cerrillo, I.; Fernández-Pachón, M.S.; Collado-González, J.; Escudero-López, B.; Berná, G.; Herrero-Martín, G.; Ferreres, F.; Gil-Izquierdo, A. Effect of Fermentation and Subsequent Pasteurization Processes on Amino Acids Composition of Orange Juice. Plant Foods Hum. Nutr. 2015, 70, 153–159. [Google Scholar] [CrossRef]
- Salvo Romero, E.; Alonso Cotoner, C.; Pardo Camacho, C.; Casado Bedmar, M.; Vicario, M. The intestinal barrier function and its involvement in digestive disease. Rev. Esp. Enferm. Dig. 2015, 107, 686–693. [Google Scholar] [CrossRef]
- Cheru, L.; Saylor, C.F.; Lo, J. Gastrointestinal Barrier Breakdown and Adipose Tissue Inflammation. Curr. Obes. Rep. 2019, 8, 165–174. [Google Scholar] [CrossRef] [PubMed]
- Cui, Y.; Wang, Q.; Chang, R.C.; Zhou, X.; Xu, C. Intestinal Barrier Function−Non-alcoholic Fatty Liver Disease Interactions and Possible Role of Gut Microbiota. Agric. Food Chem. 2019, 67, 2754–2762. [Google Scholar] [CrossRef] [PubMed]
- Julio-Pieper, M.; Bravo, J.A. Intestinal Barrier and Behavior. Int. Rev. Neurobiol. 2016, 131, 127–141. [Google Scholar] [CrossRef] [PubMed]
- Bischoff, S.C.; Barbara, G.; Buurman, W.; Ockhuizen, T.; Schulzke, J.D.; Serino, M.; Tilg, H.; Watson, A.; Wells, J.M. Intestinal permeability—A new target for disease prevention and therapy. BMC Gastroenterol. 2014, 14, 189. [Google Scholar] [CrossRef] [PubMed]
- Di Cerbo, A.; Palmieri, B.; Aponte, M.; Morales-Medina, J.C.; Iannitti, T. Mechanisms and therapeutic effectiveness of lactobacilli. J. Clin. Pathol. 2016, 69, 187–203. [Google Scholar] [CrossRef]
- Sniffen, J.C.; McFarland, L.V.; Evans, C.T.; Goldstein, E.J.C. Choosing an appropriate probiotic product for your patient: An evidence-based practical guide. PLoS ONE 2018, 13. [Google Scholar] [CrossRef]
- Sambuy, Y.; De Angelis, I.; Ranaldi, G.; Scarino, M.L.; Stammati, A.; Zucco, F. The Caco-2 cell line as a model of the intestinal barrier: Influence of cell and culture-related factors on Caco-2 cell functional characteristics. Cell Biol. Toxicol. 2005, 21, 1–26. [Google Scholar] [CrossRef]
- Devriese, S.; Van den Bossche, L.; Van Welden, S.; Holvoet, T.; Pinheiro, I.; Hindryckx, P.; De Vos, M.; Laukens, D. T84 monolayers are superior to Caco-2 as a model system of colonocytes. Histochem. Cell Biol. 2017, 148, 85–93. [Google Scholar] [CrossRef]
- Monteagudo-Mera, A.; Rastall, R.A.; Gibson, G.R.; Charalampopoulos, D.; Chatzifragkou, A. Adhesion mechanisms mediated by probiotics and prebiotics and their potential impact on human health. Appl. Microbiol. Biotechnol. 2019, 103, 6463–6472. [Google Scholar] [CrossRef]
- Martín, R.; Chamignon, C.; Mhedbi-Hajri, N.; Chain, F.; Derrien, M.; Escribano-Vasquez, U.; Garault, P.; Cotillard, A.; Pham, H.P.; Chervaux, C.; et al. The potential probiotic Lactobacillus rhamnosus CNCM I-3690 strain protects the intestinal barrier by stimulating both mucus production and cytoprotective response. Sci. Rep. 2019, 9. [Google Scholar] [CrossRef]
- Leteurtre, E.; Gouyer, V.; Rousseau, K.; Moreau, O.; Barbat, A.; Swallow, D.; Huet, G.; Lesuffleur, T. Differential mucin expression in colon carcinoma HT-29 clones with variable resistance to 5-fluorouracil and methotrexate. Biol. Cell 2004, 96, 145–151. [Google Scholar] [CrossRef]
- Laparra, J.M.; Sanz, Y. Comparison of in vitro models to study bacterial adhesion to the intestinal epithelium. Lett. Appl. Microbiol. 2009, 49, 695–701. [Google Scholar] [CrossRef] [PubMed]
- Salas-Jara, M.J.; Ilabaca, A.; Vega, M.; García, A. Biofilm Forming Lactobacillus: New Challenges for the Development of Probiotics. Microorganisms 2016, 4, 35. [Google Scholar] [CrossRef] [PubMed]
- Cheow, W.S.; Kiew, T.Y.; Hadinoto, K. Controlled release of Lactobacillus rhamnosus biofilm probiotics from alginate-locust bean gum microcapsules. Carbohydr. Polym. 2014, 103, 587–595. [Google Scholar] [CrossRef] [PubMed]
- Lebeer, S.; Verhoeven, T.L.A.; Vélez, M.P.; Vanderleyden, J.; De Keersmaecker, S.C.J. Impact of Environmental and Genetic Factors on Biofilm Formation by the Probiotic Strain Lactobacillus rhamnosus GG. Appl. Environ. Microbiol. 2007, 73, 6768–6775. [Google Scholar] [CrossRef]
- Flemming, H.-C.; Wingender, J. The biofilm matrix. Nat. Rev. Microbiol. 2010, 8, 623–633. [Google Scholar] [CrossRef]
- Lebeer, S.; Claes, I.J.J.; Verhoeven, T.L.A.; Vanderleyden, J.; De Keersmaecker, S.C.J. Exopolysaccharides of Lactobacillus rhamnosus GG form a protective shield against innate immune factors in the intestine. Microb. Biotechnol. 2011, 4, 368–374. [Google Scholar] [CrossRef]
- Caggianiello, G.; Kleerebezem, M.; Spano, G. Exopolysaccharides produced by lactic acid bacteria:from health-promoting benefits to stress tolerance mechanisms. Appl. Microbiol. Biotechnol. 2016. [Google Scholar] [CrossRef]
- Dertli, E.; Mayer, M.J.; Narbad, A. Impact of the exopolysaccharide layer on biofilms, adhesion and resistance to stress in Lactobacillus johnsonii FI9785. BMC Microbiol. 2015, 15. [Google Scholar] [CrossRef]
- Foley, M.H.; O’Flaherty, S.; Barrangou, R.; Theriot, C.M. Bile salt hydrolases: Gatekeepers of bile acid metabolism and host-microbiome crosstalk in the gastrointestinal tract. Plos Pathog. 2019, 15, 1007581. [Google Scholar] [CrossRef]
- Bustos, A.Y.; Font de Valdez, G.; Fadda, S.; Taranto, M.P. New insights into bacterial bile resistance mechanisms: The role of bile salt hydrolase and its impact on human health. Food Res. Int. 2018, 112, 250–262. [Google Scholar] [CrossRef]
- Begley, M.; Hill, C.; Gahan, C.G.M. Bile Salt Hydrolase Activity in Probiotics. Appl. Environ. Microbiol. 2006, 72, 1729–1738. [Google Scholar] [CrossRef] [PubMed]
- Chand, D.; Avinash, V.S.; Yadav, Y.; Pundle, A.V.; Suresh, C.G.; Ramasamy, S. Molecular features of bile salt hydrolases and relevance in human health. Biochim. Biophys. Acta Gen. Subj. 2017, 186, 2981–2991. [Google Scholar] [CrossRef] [PubMed]
- Yunes, R.A.; Poluektova, E.U.; Vasileva, E.V.; Odorskaya, M.V.; Marsova, M.V.; Kovalev, G.I.; Danilenko, V.N. A Multi-strain Potential Probiotic Formulation of GABA-Producing Lactobacillus plantarum 90sk and Bifidobacterium adolescentis 150 with Antidepressant Effects. Probiotics Antimicrob. Proteins 2019. [Google Scholar] [CrossRef] [PubMed]
- Pérez-Berezo, T.; Pujo, J.; Martin, P.; Le Faouder, P.; Galano, J.-M.; Guy, A.; Knauf, C.; Tabet, J.C.; Tronnet, S.; Barreau, F.; et al. Identification of an analgesic lipopeptide produced by the probiotic Escherichia coli strain Nissle 1917. Nat. Commun. 2017, 8. [Google Scholar] [CrossRef] [PubMed]
- Bravo, J.A.; Forsythe, P.; Chew, M.V.; Escaravage, E.; Savignac, H.M.; Dinan, T.G.; Bienenstock, J.; Cryan, J.F. Ingestion of Lactobacillus strain regulates emotional behavior and central GABA receptor expression in a mouse via the vagus nerve. Proc. Natl. Acad. Sci. USA 2011, 108, 16050–16055. [Google Scholar] [CrossRef] [PubMed]
- Rayavarapu, B.; Tallapragada, P. Statistical optimization of γ-aminobutyric acid production by response surface methodology and artificial neural network models using Lactobacillus fermentum isolated from palm wine. Biocatal. Agric. Biotechnol. 2019, 22. [Google Scholar] [CrossRef]
- Gharehyakheh, S.; Rad, A.H.E.; Nateghi, L.; Varmira, K. Production of GABA-enriched honey syrup using Lactobacillus bacteria isolated from honey bee stomach. J. Food Process. Preserv. 2019, 43. [Google Scholar] [CrossRef]
- Song, Y.; Shenwu, M.; Dhossche, D.M.; Liu, Y.-M. A capillary liquid chromatographic/tandem mass spectrometric method for the quantification of γ-aminobutyric acid in human plasma and cerebrospinal fluid. J. Chromatogr. B Analyt. Technol. Biomed. Life Sci. 2005, 814, 295–302. [Google Scholar] [CrossRef]
- Lu, M.-J.; Chiu, T.-C.; Chang, P.-L.; Ho, H.-T.; Chang, H.-T. Determination of glycine, glutamine, glutamate, and γ-aminobutyric acid in cerebrospinal fluids by capillary electrophoresis with light-emitting, diode-induced fluorescence detection. Anal. Chim. Acta 2005, 538, 143–150. [Google Scholar] [CrossRef]
- Cortes-Saladelafont, E.; Molero-Luis, M.; Cuadras, D.; Casado, M.; Armstrong-Moron, J.; Yubero, D.; Montoya, J.; Artuch, R.; Garcia-Cazorla, A. Gamma-aminobutyric acid levels in cerebrospinal fluid in neuropaediatric disorders. Dev. Med. Child. Neurol. 2018, 60, 780–792. [Google Scholar] [CrossRef] [PubMed]
- Zheng, H.-F.; Wang, W.-Q.; Li, X.-M.; Rauw, G.; Baker, G.B. Body fluid levels of neuroactive amino acids in autism spectrum disorders: A review of the literature. Amino Acids 2017, 49, 57–65. [Google Scholar] [CrossRef] [PubMed]
- Wu, J.-L.; Yu, S.-Y.; Wu, S.-H.; Bao, A.-M. A sensitive and practical RP-HPLC-FLD for determination of the low neuroactive amino acid levels in body fluids and its application in depression. Neurosci. Lett. 2016, 11, 32–37. [Google Scholar] [CrossRef] [PubMed]
- He, S.; Zhang, X.; Qu, S. Glutamate, Glutamate Transporters, and Circadian Rhythm Sleep. ACS Chem. Neurosci. 2019, 10, 175–181. [Google Scholar] [CrossRef] [PubMed]

| Lactobacillus Species | Strains | Abbreviation | Origin | Growth Conditions |
|---|---|---|---|---|
| L. rhamnosus | LGG | LGG | Lesaffre | Facultative anerobia MRS 37 °C |
| L. casei | LC03 (DSM27537) | LC03 | Probiotical | |
| L. rhamnosus | LR04 (DSM16605) | LR04 | Probiotical | |
| L. plantarum | CNCM I-4459 (LP-Onlly) | CNCM | Novanat | |
| L. plantarum | CIP 104450 | CIP | Institut Pasteur | |
| L. paracasei | ROQB1 | ROQB1 | Roquette Frères |
| Lactobacillus Species | Strains | TDCA Hydrolase Activity/Growth | GDCA Hydrolase Activity/Growth |
|---|---|---|---|
| L. rhamnosus | LGG | −/+ | −/− |
| L. rhamnosus | LR04 | −/+ | −/− |
| L. plantarum | CNCM | −/+ | +/+ |
| L. casei | LC03 | −/+ | −/− |
| L. plantarum | CIP | −/+ | −/− |
| L. paracasei | ROQB1 | −/+ | +/+ |
© 2020 by the authors. Licensee MDPI, Basel, Switzerland. This article is an open access article distributed under the terms and conditions of the Creative Commons Attribution (CC BY) license (http://creativecommons.org/licenses/by/4.0/).
Share and Cite
Chamignon, C.; Guéneau, V.; Medina, S.; Deschamps, J.; Gil-Izquierdo, A.; Briandet, R.; Mousset, P.-Y.; Langella, P.; Lafay, S.; Bermúdez-Humarán, L.G. Evaluation of the Probiotic Properties and the Capacity to Form Biofilms of Various Lactobacillus Strains. Microorganisms 2020, 8, 1053. https://doi.org/10.3390/microorganisms8071053
Chamignon C, Guéneau V, Medina S, Deschamps J, Gil-Izquierdo A, Briandet R, Mousset P-Y, Langella P, Lafay S, Bermúdez-Humarán LG. Evaluation of the Probiotic Properties and the Capacity to Form Biofilms of Various Lactobacillus Strains. Microorganisms. 2020; 8(7):1053. https://doi.org/10.3390/microorganisms8071053
Chicago/Turabian StyleChamignon, Célia, Virgile Guéneau, Sonia Medina, Julien Deschamps, Angel Gil-Izquierdo, Romain Briandet, Pierre-Yves Mousset, Philippe Langella, Sophie Lafay, and Luis G. Bermúdez-Humarán. 2020. "Evaluation of the Probiotic Properties and the Capacity to Form Biofilms of Various Lactobacillus Strains" Microorganisms 8, no. 7: 1053. https://doi.org/10.3390/microorganisms8071053
APA StyleChamignon, C., Guéneau, V., Medina, S., Deschamps, J., Gil-Izquierdo, A., Briandet, R., Mousset, P.-Y., Langella, P., Lafay, S., & Bermúdez-Humarán, L. G. (2020). Evaluation of the Probiotic Properties and the Capacity to Form Biofilms of Various Lactobacillus Strains. Microorganisms, 8(7), 1053. https://doi.org/10.3390/microorganisms8071053









